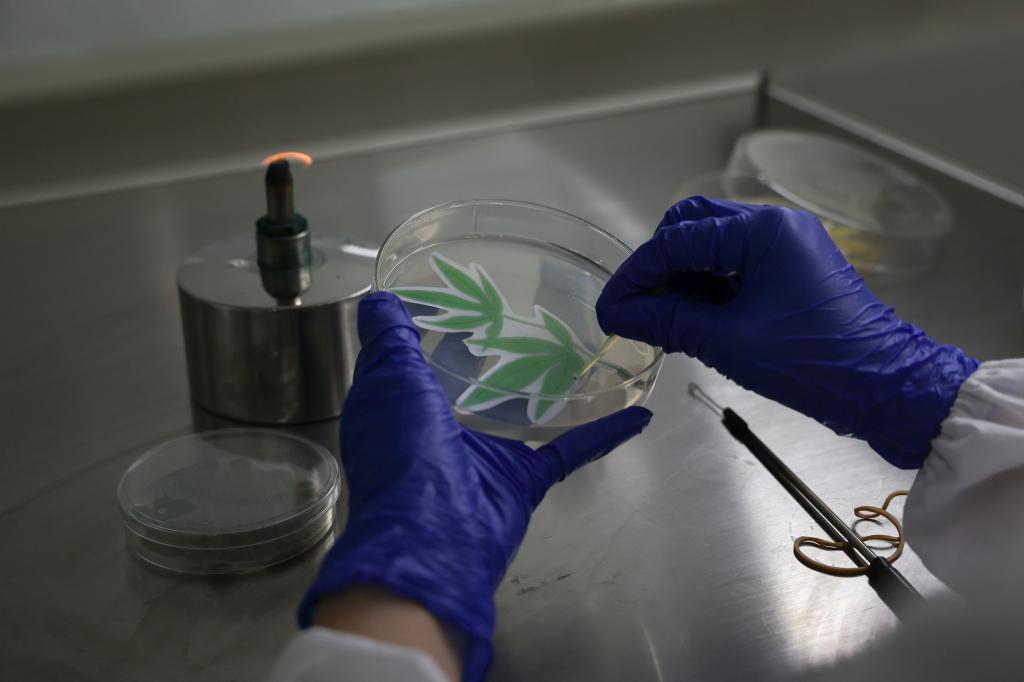

5月17日中午12点,南京农业大学生命科学学院“走进实验室”活动顺利开展。本次活动包括三个环节:开展琼脂艺术大赛,参观朱静老师实验室、动物标本馆和李周坤老师实验室。
第七届琼脂艺术大赛接种环节初赛在生科楼C5039举行,参赛选手们进行细菌接种工作,以艺术创作的形式完成自己的作品。该活动将趣味性与专业性结合,让同学们更加熟悉细菌接种的流程,同时打造了浓厚的实验氛围。

下午2点,此次活动来到了朱静老师的办公室。老师对大型食用真菌进行了初步的介绍与讲解;,接着同学们到实验室参观真菌,观察真菌形态特征与培养环境,了解与真菌有关的科研项目。随后在动物标本馆,讲解员们为同学们带来了一场生动有趣的动物科普课程。他们先向同学们讲解了各种动物的生存环境和习性,引导大家对动物的生态环境有了更深刻的认识。讲解员们带领着同学们依次参观了各类动物标本,生动地介绍了这些动物的各项特征和习性。最后来到李周坤老师的实验室,老师对黏细菌和塑料降解环境保护进行了更深入的探讨与分析,让同学们对此的认识更进一层细菌有了进一步了解,同时提升培养了他们对这方面知识的兴趣。




走进实验室活动内容丰富多样,层层递进。,本次活动旨在为学生提供了解实验室的平台,通过请专家老师分享研究经验与成果,科普实验室专业知识,进一步营造学术氛围,加强实验室建设,推动学生科研项目的发展,提高专业水平。
图:刘昊燃、刘晗
文:郑城瑶
编:张恒睿